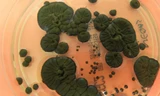
Loài nấm sinh sôi ở ‘vùng chết’ có thể bảo vệ phi hành gia

“Chú bướm sao Hỏa” này được phát hiện ở khu vực Idaeus Fossae, nơi tác động từ vụ va chạm với thiên thạch đã hất đất đá văng theo hai hướng ngược nhau, tạo nên hình dạng giống đôi cánh bướm đang mở. Hình ảnh này được ESA công bố ngày 3/12 vừa qua.
Theo nhóm nghiên cứu sứ mệnh Mars Express, điều này khác thường bởi đa số va chạm đẩy đất đá văng ra theo mọi hướng. Nhưng với góc va chạm nông, vật liệu chỉ bị hất văng theo hai dải rõ rệt, tạo nên hình dạng đặc biệt.
Hố này rộng khoảng 20 km và dài khoảng 15 km, nằm ở vùng trũng phía bắc của sao Hỏa. Kích thước và cấu trúc độc đáo của hố cho thấy thiên thạch tạo ra nó có kích cỡ đáng kể.
Một trong những đặc điểm bất ngờ của hố là sự hiện diện của vật chất bị hóa lỏng mà các nhà khoa học cho rằng có thể đã trộn lẫn với đất đá, vì từng có nước hoặc băng dưới bề mặt sao Hỏa.
Một số mảnh vỡ tạo nên phần cánh có vẻ mượt hơn và tròn hơn, giống như một trận lở bùn.
Theo báo cáo của ESA, điều này cho thấy cú va chạm có thể đã làm tan chảy lớp băng dưới bề mặt sao Hoả, khiến vật chất chảy lan.
Khả năng chất lỏng có mặt trong quá trình hình thành khu vực này đặc biệt quan trọng, vì đó có thể là manh mối về những yếu tố có thể từng tạo nên sự sống. Sự hiện diện của nước, kể cả ở dạng băng, vẫn luôn là trọng tâm của các sứ mệnh khám phá sao Hỏa mà một số cường quốc đã và đang triển khai.
Dù hố hình bướm là tâm điểm chú ý, khu vực xung quanh cũng có nhiều đặc điểm địa chất đáng quan tâm. Ở phía bên trái của hố, cảnh quan chủ yếu là các thềm đá dốc và đỉnh phẳng - tàn tích của hoạt động núi lửa.
Theo ESA, khu vực này có lẽ từng trải qua khá nhiều hoạt động núi lửa, với các lớp dung nham và tro tích tụ qua thời gian rồi bị chôn vùi dưới những lớp vật chất khác.
Khu vực xung quanh cũng xuất hiện các dải nhăn – hình thành khi dung nham nguội đi và co lại, củng cố lập luận rằng cảnh quan trước kia chủ yếu là núi lửa, cho thấy hành tinh này từng diễn ra nhiều hoạt động địa chất hơn hiện tại.
Tàu Mars Express quay quanh sao Hỏa từ năm 2003, làm nhiệm vụ lập bản đồ bề mặt hành tinh đỏ với độ phân giải chưa từng có.